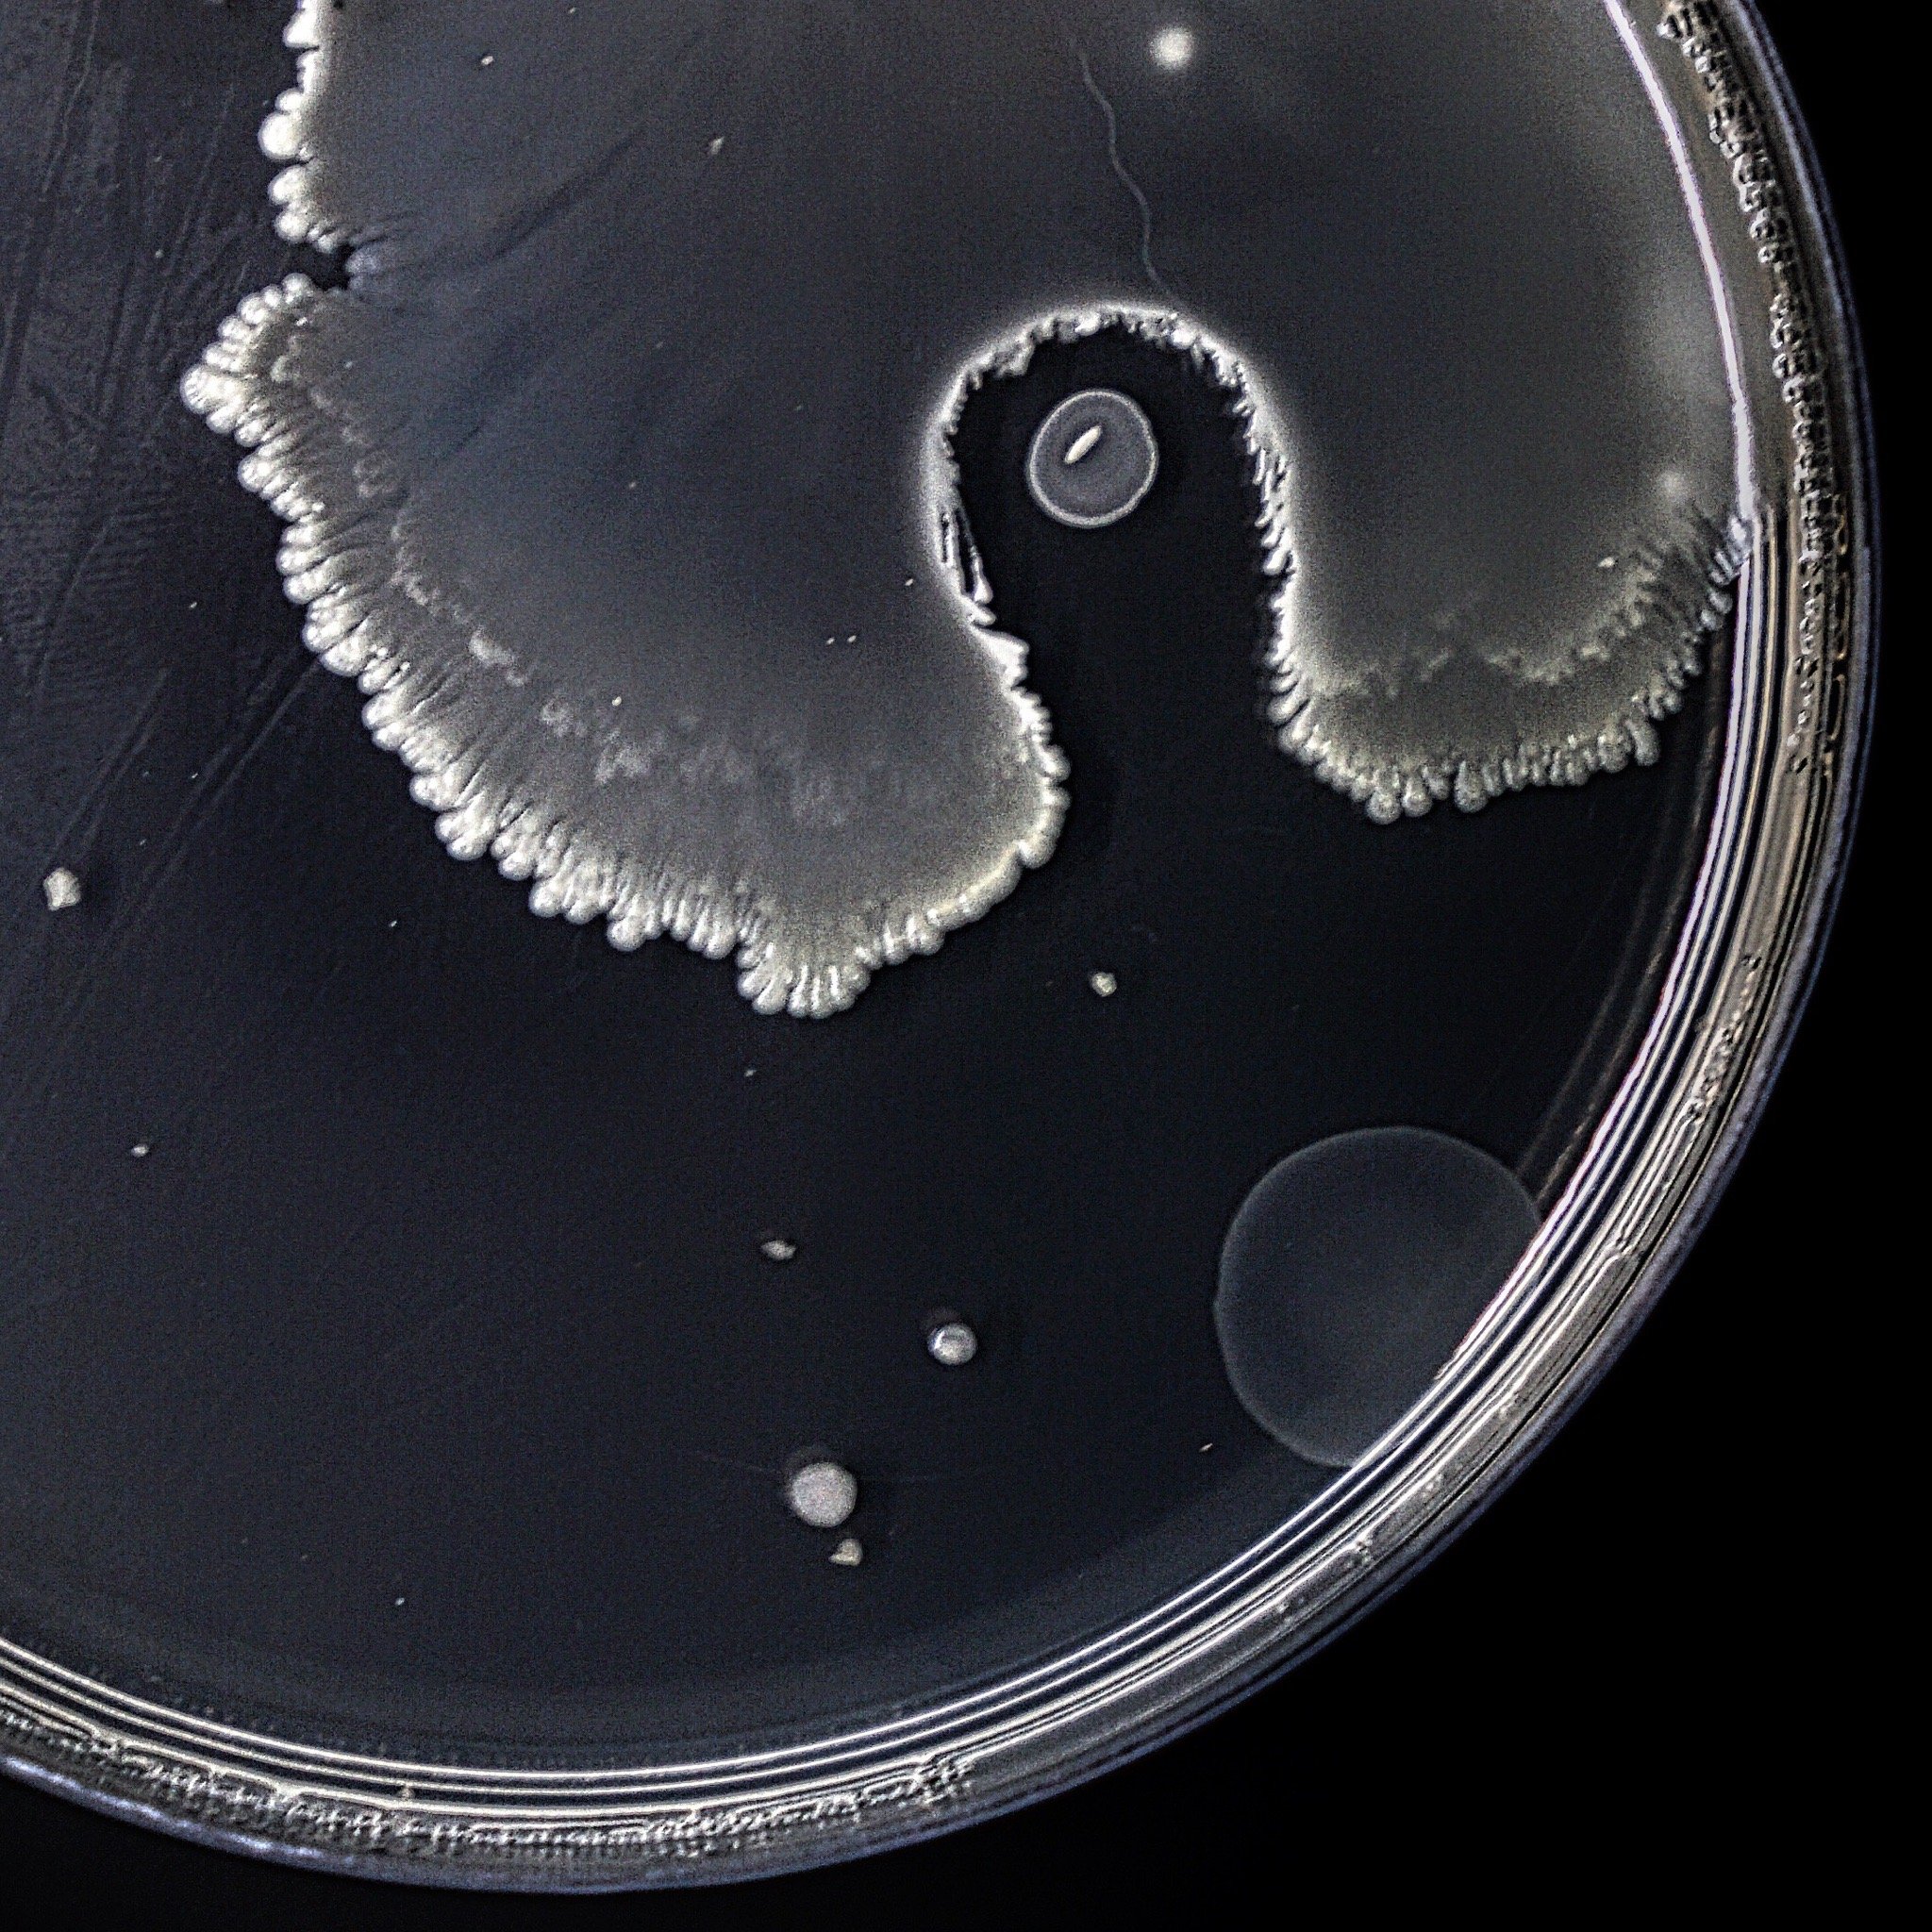

Microbiolab – Agricultural Microbiology Platform
Microbiolab is an organization based in Ecuador specializing in agricultural microbiology analysis, bioinput production, and scientific education on microorganisms. Founded in 2015, it has developed through field research across different agricultural regions, continuously improving the application and management of beneficial microorganisms.
The platform focuses on promoting a science-based approach to agriculture, helping farmers, technicians, and professionals understand and effectively use microorganisms in crop systems.
Main Areas of Work
Microbiological analysis applied to agriculture
Production of microbial bioinputs
Scientific dissemination and training in microbiology
Educational Offer
Microbiolab provides a wide range of digital learning resources, including:
Online courses on topics such as:
Microbial bioinput production
Isolation and identification of microorganisms
Trichoderma biotechnology
Design of biofactories
Agricultural microbiology techniques
Books and technical manuals, including Applied Microbiology in Agriculture
Free guides and educational materials to support learning at all levels
Mission and Vision
The organization aims to make microbiological knowledge accessible and practical, ensuring that microbial technologies are applied efficiently and correctly in agriculture. It promotes the idea that microorganisms are fundamental agents capable of transforming ecosystems and improving agricultural productivity.
Founder
Microbiolab is led by María Esther Cortez Pazmiño, a microbiologist specialized in agricultural microbiology and agroecology, with experience in laboratory analysis, quality control, and microbial research applied to agriculture.